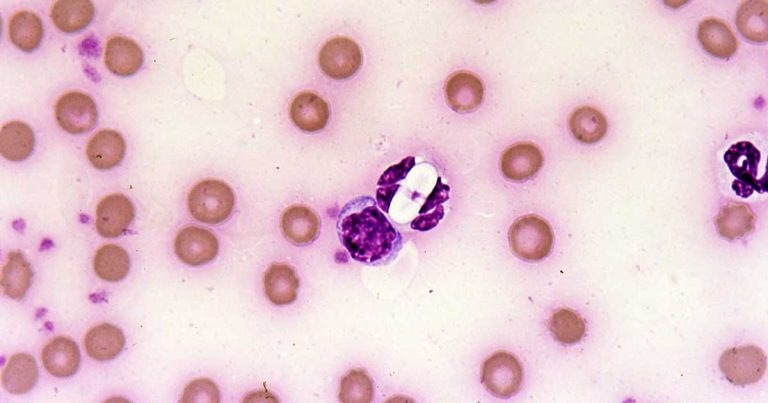
Small animal parasite diagnosis

3 Apr 2018
Ian Wright discusses methods of identifying and examining parasitic infections in cats and dogs, such as ticks and fleas.
Image: Pedro Serra / NationWide Labs
Cats and dogs are infected with a wide range of parasites, many of which are capable of causing disease and contributing to existing clinical syndromes. Others have zoonotic potential. Diagnosis is important for correct effective treatment to be initiated, efficacy of treatment to be monitored and screening for subclinical parasitic infections to be carried out. A wide range of diagnostic tools are available to first opinion practitioners that may be used on a variety of sample types.
This article considers some of the diagnostic techniques available for parasite diagnosis using faecal, urine, blood and skin sampling. Identification of some of the more common parasites that may be encountered are also considered.
Cats and dogs are exposed to a wide range of parasites, some of which are visible to the naked eye on close examination of the skin and coat, such as ticks and fleas.

Others, however – such as Toxocara species, Angiostrongylus vasorum and tick-borne diseases – may cause significant disease in pets or present zoonotic risks to owners without being externally visible or presenting with pathognonomic signs. Routine preventive treatment is required to control some of these parasites based on risk assessment, but this is not possible for many parasites, such as Giardia and Toxoplasma, which may cause both significant disease and zoonotic risk.
Even where routine preventive treatments are possible and desirable, diagnostic testing is useful in surveillance monitoring the effectiveness of parasite control programmes. Rapid diagnosis in clinical cases improves prognostic outcomes and helps limit parasite spread. Screening of imported dogs for exotic tick-borne diseases helps maintain biosecurity and plan for the potential development of long-term disease in the patient.
Parasite diagnostics may be carried out on a variety of tissues and bodily secretions, but the most commonly used to yield rapid diagnostic results are faeces, urine, blood and skin testing.
Many parasites intermittently pass ova, cysts or larvae in the faeces, which can then be detected by faecal analysis. Shedding of larvae and ova is often intermittent, so, ideally, samples should be collected over three consecutive days for increased diagnostic sensitivity.

If the sample is collected by the client, it must be picked up as soon as it is passed. If left on the ground, faeces rapidly become contaminated with free-living nematodes (Figure 1) and mites (Figure 2). These may be confused with parasitic life stages and will also obscure the field of view during microcscopic examination, if present in large numbers. Once collected, samples should either be examined immediately or stored at 4°C to prevent hatching of ova or larval development. Hookworm eggs will rapidly larvate and hatch if faeces are left at room temperature.
Faeces can be examined for parasite ova and larvae by the following methods.
Direct smear is a very simple technique and can be useful for the detection of protozoal cysts in the faeces, such as Giardia or Isospora species. Shedding of these cysts is intermittent, but when contributing to diarrhoea, syndromes are often present in large numbers – especially in the case of Isospora species.
Direct smears only analyse very small volumes of faeces and as a result are considered too insensitive for the detection of helminth ova which are passed in relatively few numbers. Lungworm larvae, such as Crenosoma vulpis and A vasorum, may be detected and is useful as an initial screen for these parasites, but the low sensitivity (54% to 61%) for the detection of lungworm by this method means it should not be relied on as a sole test, if negative (Humm and Adamantos, 2010).
A faecal sample approximately 1mm3 (the size of a match head) is mixed with a drop of water on a microscope slide and examined with a cover slip under the microscope. The addition of a drop of Lugol’s iodine will aid in the detection of Giardia cysts, which will be stained yellow.
Faecal flotation allows much larger volumes of faeces to be examined by concentrating ova present in the faeces in small volumes of liquid, while eliminating debris. This technique may still have diagnostic sensitivities as low as 60% for some ova, such as Toxocara species (Wolfe et al, 2001), but increases with pooled samples over three days. Some parasitic diseases, such as anaemia and gastroenteritis caused by Ancylostoma caninum, will occur before ova shedding and may, therefore, be missed by faecal analysis.
Many different flotation methodologies are described in the literature, but an example is described as follows:
1. The faecal sample is mixed with water (approximately 10ml per gram of faeces) and stirred to form a suspension.
2. The suspension is then poured through a tea strainer to remove very large particles and decanted into centrifuge tubes. These can either be centrifuged at 1,500rpm for 15 minutes or allowed to stand for 20 minutes.
3. The water is removed and the tubes half filled with flotation solution and mixed.
4. Each tube is filled with flotation solution until a meniscus is formed at the top of the tube.
5. A cover slip is added, contacting the flotation solution.
6. The tubes are centrifuged for 10 minutes or allowed to stand again for 30 minutes.
7. Once these steps are complete, the cover slips are lifted off the tubes and examined at ×40 magnification under the microscope.

The flotation solution can either be sugar solution or zinc sulphate. Zinc sulphate is less sticky and easier to handle, but slides tend to dry out and crystallise very quickly. Distortion of ova can also occur, making identification more difficult. Centrifugation of samples increases test sensitivity, but many practices do not possess centrifuges with free swinging buckets required to keep the cover slips in place. Allowing the samples to settle over time is still useful as an initial test, but some loss in sensitivity will occur.
The Baermann technique is used for the detection of larvae in faeces. One of the advantages of this technique is it requires inexpensive equipment – much of which can be reused for further tests (Figure 3).
The technique is as follows
1. A rubber hose is attached to a funnel. This connection needs to be watertight over several hours, so waterproof tape may be required depending on how tight the seal is.
2. The two are suspended on a clamp stand with enough space underneath the tubing to allow collection of samples.
3. A clamp (or bull clip) is placed on the end of the tube. This should be able to be easily opened and closed to allow collection of the sample without spillage and possible loss of larvae.
4. Warm water is placed into a funnel until it is mostly filled. Enough space must be left to suspend the faecal sample in the water without overflow.
5. The faecal sample is wrapped in gauze and placed in the water in the funnel. It is easier to manipulate and prevent the sample from sinking and blocking the funnel if a stick or thin metal pole is placed through the gauze, so it may be suspended in the water.
6. The warmth of the water activates the larvae in the sample, but they are unable to swim upwards against gravity. As a result, they drop through the gauze and down the funnel into the tubing.
7. After 12 to 24 hours the clamp is released and 10ml to 15ml of water can be drawn off into a test tube. The sample can then be centrifuged at 1,500 revolutions per minute for one minute and the resultant plug examined for larvae. If a centrifuge is not available, the larvae can be allowed to settle to the bottom of the tube over an 8 to 12 hour period.
8. Adding Lugol’s iodine before examination kills the larvae, making identification easier.
Most common ova and larvae in the faeces can be identified by these methods.
Examples include:

Cysts of Giardia species are immediately infective, whereas Isospora species cysts need to sporulate in damp, humid conditions before infection can occur. Isospora canis oocysts are typically 36×30µm and Isospora felis oocysts slightly larger (45×30µm). If faecal samples are not fresh when examined or have not been refrigerated then the oocysts will sporulate, changing their appearance (Figure 4).
Isospora species infection in puppies and kittens is often associated with diarrhoea, so identification of large numbers is significant in clinical cases. Giardia cysts are small (approximately 15µm) multinucleated ova with a flagellum sometimes visible crossing the ova in an “S” shape. Many cats and dogs are subclinical carriers of Giardia species, but infection can contribute to diarrhoea syndromes. It has low zoonotic potential unless pets have been exposed to human infection, but if the organism is detected good hand hygiene is advised.
Toxocara canis ova (Figure 5) are typically 87×75µm with Toxocara cati ova being smaller (75×65µm). They are rough shelled, with Toxascaris leonine ova being smooth shelled, but a much less common parasite. Heavy burdens may contribute to diarrhoea syndromes and loss of body condition in puppies and kittens, but their presence is rarely of clinical significance in adults.
Ova in fresh faeces will be unembryonated and, therefore, pose no zoonotic risk, but will lead to environmental contamination and public health risk once embryonation occurs. Some potential exists for embryonation in the coat (Wolfe and Wright, 2003; Roddie et al, 2008).
Ancylostoma species and Uncinaria stenocephala are hookworms (Figure 6) with U stenocephala in dogs and Ancylostoma tubaeforme in cats being endemic in the UK.
Hookworm ova are strongyle in appearance with an oval shape, thin outer wall and a morulated nucleus. In theory, U stenocephala ova are larger (70×45µm as opposed to 60×40µm), but significant overlap exists.
If faecal samples are not fresh when examined or have not been refrigerated, ova will larvate (Figure 7) or hatch. The presence of strongyle ova in the faeces may suggest infection in contributing to loss of condition or diarrhoea syndromes and treatment is indicated. Severe disease caused by A caninum is likely to occur before ova shedding and anaemia can occur in groups of infected puppies, with potentially life threatening consequences.
Trichuris vulpis eggs, if seen, are lemon shaped with bipolar plugs, but rarely seen in the UK, with the exception of occasional focal outbreaks centred round kennels and breeding establishments.
A vasorum larvae are typically coiled and active (Figure 8). They can be distinguished from other lungworm larvae from the characteristic notch and kink at the end of the tail (Figure 9).

A vasorum can cause a variety of disease syndromes, including bronchitis, coagulopathies, neuropathies and cardiac disease. The presence of these signs, in combination with A vasorum larvae, is strongly indicative of clinical angiostrongylosis. If signs are absent, infected dogs represent a reservoir of infection, contaminating the environment for other dogs, and still warrant treatment to eliminate the parasite.
Crenosoma vulpis larvae can be differentiated from other lungworm larvae by their straight, pointed tail. Infections can be subclinical or vary in severity from bronchitis to bronchopneumonia. The combination of these signs and the presence of larvae indicate treatment.
Oslerus osleri and Aelurostrongylus abstrusus, lungworms of dogs and cats respectively, are closely related and generally of lower pathological significance than A vasorum and C vulpis. If present, they can be categorised by a distinctive “S” shape to the tale. O osleri has long been associated with loss of performance in racing dogs and, therefore, treatment may be warranted or if associated with a chronic cough. Similarly, A abstrusus may be associated with bronchitic syndromes in cats.
Antigens of some parasites can be detected in faeces, aiding in their diagnosis. Patient-side testing for Giardia faecal antigens is a highly sensitive and specific test, as are commercially launched test kits for intestinal roundworms, whipworms and hookworms. These tests allow infections to be detected when ova shedding is not occurring, but may detect subclinical carrier states, so must be interpreted with caution.
Coproantigen testing is also possible for Echinococcus species, which is vitally important for screening programmes for these serious zoonoses, but are too expensive to be practical for individual pet testing in first opinion practice.
Although urine is rarely used as a primary method of parasite diagnosis, it can reveal signs of infection and yield prognostic information. Urine should be examined fresh. Even if collected by clients at home, they should be encouraged to present the urine for examination as quickly as possible.
Before microscopic examination is performed, the gross characteristics of the sample can be assessed. Dilute urine will be very pale, then darken as it becomes more concentrated. Haemoglobinuria will give the urine a dark red/brown appearance (Figure 10) and is a sign of haemolytic anaemia. Babesiosis should be considered as a differential in these cases. Bilirubin in jaundiced patients will give the urine a yellow tinge and may also be an indicator of haemolytic anaemia or a hepatopathy. When immune-mediated, parasitic diseases potentially lead to glomerulonephritis, such as with Lyme disease (Lyme nephritis) and leishmaniosis, and proteinuria is a very useful prognostic indicator.

Capillaria plica is a bladder worm of canids transmitted through the consumption of earthworm intermediate hosts. It is rarely seen in domestic dogs, but, if present, is often subclinical and an incidental finding. Occasionally, infection can cause pain on urination, haematuria and dysuria secondary to pyelonephritis or cystitis. Eggs may be seen in the urine of infected dogs and have distinctive bipolar plugs.
Light microscopy of blood smears forms a vital part of blood sample diagnostic work and parasitic life stages may be identified.
Blood smears are quick and simple to prepare, but require practice to perform with the correct motion, leading to an even film. They can be prepared in the following way:
1. A small drop of blood is placed on to the slide, using a capillary tube.
2. A second slide (the “spreader slide”) is placed on to the slide holding the blood drop at approximately a 30° angle.
3. The spreader slide is moved backwards until it comes into contact with the blood drop, which then spreads along the edge of the slide.
4. The spreader slide is moved forward smoothly without breaking contact with the sample slide.
5. As the movement reaches the end of the slide, a feathered edge should naturally be created if the action has been smooth and the drop of blood not too large.
6. The slide should then be air dried, fixed in methanol for three minutes then stained, either with a Romanowsky stain variant, Wright’s stain or Giemsa stain.
If samples are not going to be prepared immediately, or if samples will be sent to an external lab for blood smear preparation, they can be stored in ethylenediaminetetraacetic acid tubes.
Alternatively, samples can be prepared and air dried without fixing and staining before sending to an external lab. Parasites may be seen in red or white blood cells or extracellularly.
Rickettsia, such as Haemoplasma felis, may be seen as single inclusion bodies or in chains. If these organisms are suspected then smears should be examined fresh and over several days to maximise the chance of detecting the organism. They should not be confused with non-parasitic inclusion bodies.

Howell-Jolly bodies are blue nuclear remnants and are a common, normal finding in cats. Increased numbers are seen in splenectomised animals and in regenerative anaemia. Heinz bodies attach to the cell membrane and, again, may be a normal finding in cats. Large numbers indicate exposure to oxidant toxins, such as onions or paracetamol.
Various parasites may be seen within the white blood cells of travelled pets, such as Leishmania amastigotes, Ehrlichia canis morula and Hepatazoon species gametocytes (Figure 11).
Antibody serology is useful for the diagnosis of many protozoal and vector-borne infections, such as Leishmania infantum, Toxoplasma gondii, Ehrlichia canis and Borrelia species.
Although these tests can be highly sensitive in detecting exposure to infection, a positive result does not necessarily mean infection is present or that the organism detected is the cause of presenting clinical signs.
It can also take time for an immune response to develop to the point of serology detection, and cross reactivity with other organisms can occur. This makes antibody serology inappropriate for the detection of some parasites, such as Babesia species.
Testing for parasite antigens in blood is useful for A vasorum and Dirofilaria immitis heartworm detection.
While Baermann apparatus remains the gold standard for A vasorum infection, a pet-side antigen blood test has revolutionised A vasorum testing. Only a small volume of blood is required, and results are rapidly obtained at relatively little cost. This has made the screening of large numbers of suspected cases of angiostrongylosis more achievable in first opinion practice.
It is highly specific, but less sensitive than a Baermann test carried on pooled faecal samples collected over three days. If A vasorum infection is suspected and the pet-side antigen blood test is negative then the Baermann technique is warranted. Testing for uterine antigen secretions of female adult D immitis heartworms is a highly sensitive and specific diagnostic test in infected dogs. It is much less sensitive in cats due to the low numbers of adult heartworms present and sometimes female heartworms will be absent entirely.
PCR is a useful test in acute and active infections where antibody serology may be negative and in parasites where antibody cross reactivity occurs. It also often allows speciation of the parasite involved.
An example is Babesia species infections where PCR blood testing is highly sensitive and specific. Some parasitic infections, such as Borrelia and Leishmania species, have low sensitivity of blood PCR testing. In these cases, sampling multiple body tissues is required to increase sensitivity.
Skin scrapes and hair plucking (trichography) form a vital part of this dermatological work-up and can be simply performed in practice, often in the conscious patient.
Although these samples can be sent away to external labs, the samples can be viewed in house, with minimal preparation of the sample required. Large and numerous arthropods, such as Cheyletiella species mites, can easily be detected and identified.
Hair plucking is a very simple technique that can be performed quickly in the conscious patient. A small tuft of hair is plucked from the margins of the lesion being investigated and placed on a slide with liquid paraffin and a cover slip.
Hair plucking is useful in the identification of fur mites, lice and their eggs. It may also reveal Demodex species around the bulb of the hair, although skin scrapings are more sensitive for the diagnosis of demodicosis.
Skin scraping is also a simple technique used for the detection of skin mites. With adequate restraint, it can usually be performed in the conscious patient and samples examined rapidly, leading to rapid in-house diagnosis if mites are present in sufficient numbers. Multiple scrapes should be taken from different areas around the edge of lesions.
If Demodex species are suspected and the feet are affected, then scrapes from between the toes often yield higher numbers of mites, but may be more difficult to obtain. Periocular sites can also yield high numbers, but may require sedation. Sarcoptic mange can be difficult to detect and require deep, multiple scrapings, but the head and ears are particularly useful sites, as well as the hocks and elbows.
Ideally, hair should be clipped from the site before scraping where practical. If the site can be clipped with electric clippers then this is particularly useful for deep scrapes for burrowing mites as hair makes diagnostic depth of scrapes difficult, especially for sarcoptic mange. The skin is squeezed gently then steadied between the thumb and forefinger. Liquid paraffin is then spread over the area with a scalpel blade and the skin scraped until a capillary bleed is produced.
The material collected on the blade can then be transferred to a slide for examination, and more liquid paraffin and a cover slip added. The use of liquid paraffin has the advantage of parasites remaining alive, so movement can be detected when scanning the microscope slide, but may result in substantial skin debris obscuring the examiner’s view. This can be avoided by dry scrapings being treated with 10% potassium hydroxide before light microscopic examination, but this kills any parasites present.
Many different types of parasite may be detected by these methods and some examples are:

Demodex species: canine demodicosis is predominantly caused by Demodex canis. Female mites are up to 0.3mm long and males are up to 0.25mm. Demodex injai is at least twice the size of D canis, whereas Demodex cornei is much shorter. Whether these “long-bodied“ and “short-bodied” mites are actually separate species is a subject of some debate, but they are recognised as distinct forms. Feline demodicosis is mainly caused by Demodex cati. It is long and slender, where a less common species, Demodex gatoi, is short and broad.
The availability of highly efficacious ectoparisiticides and the need for routine deworming of many pets to prevent Toxocara species egg shedding and disease risk from A vasorum may make the need for parasite diagnosis seem increasingly redundant.
It is still vital, however, for the monitoring of treatment efficacy, as part of the work-up of clinical cases and in the screening for exotic parasites in travelled pets.
Familiarity with the diagnostic tests available and ability to run some of them in house continues to be invaluable in the assessment and treatment of parasitic infections in first opinion veterinary medicine.